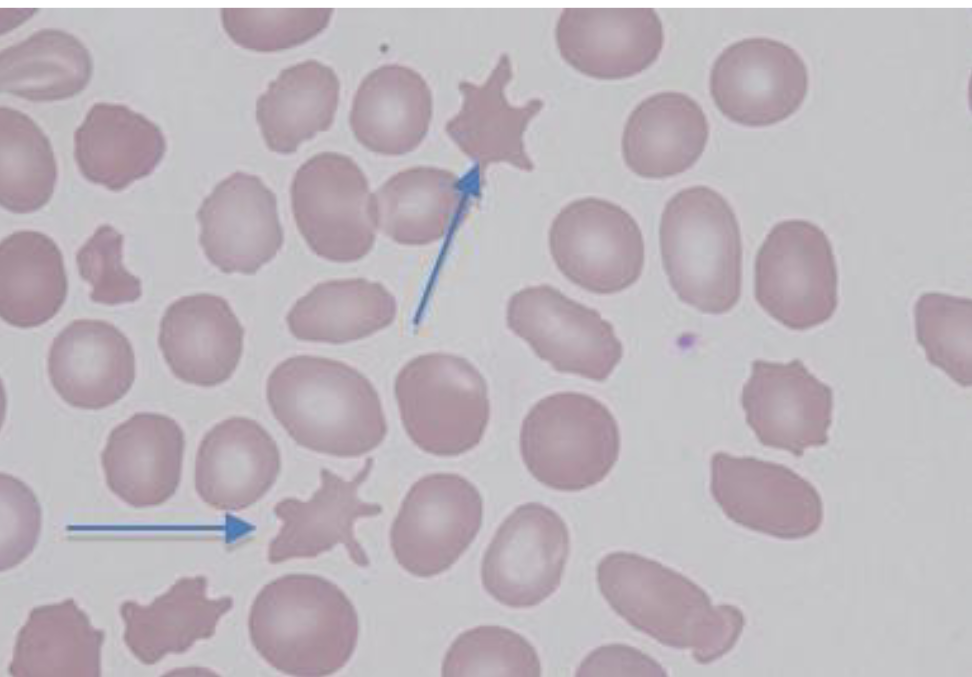
<p>Acanthocytes </p>
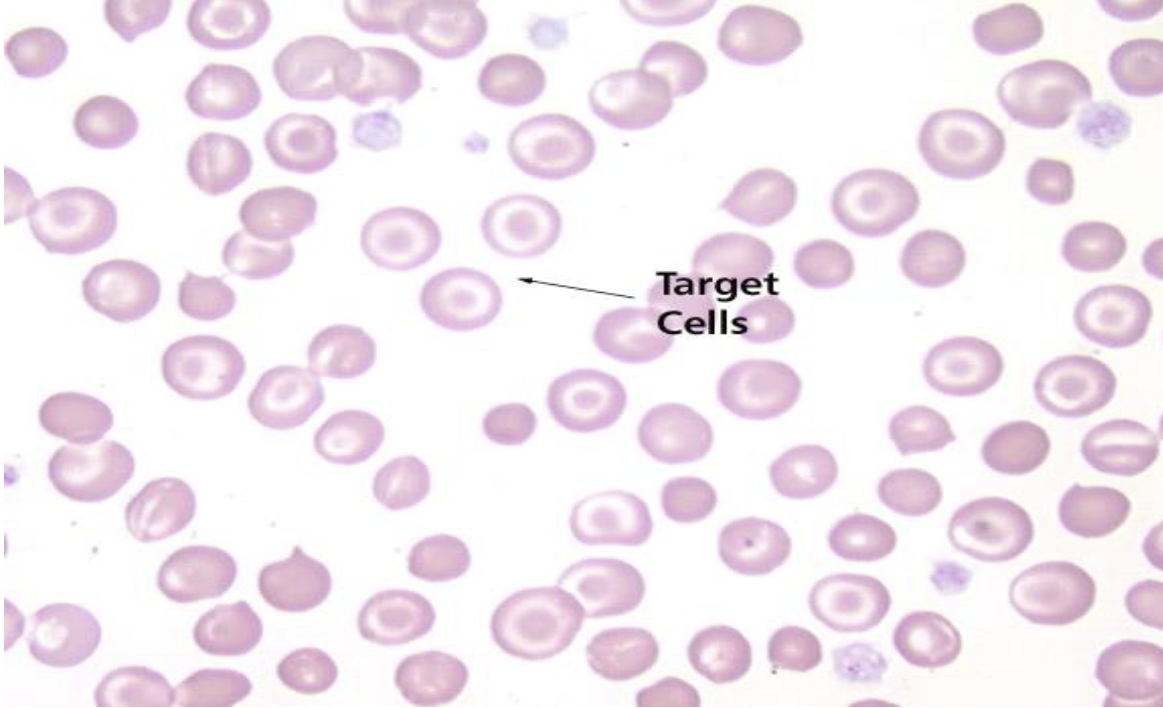
<p>Target Cells </p>
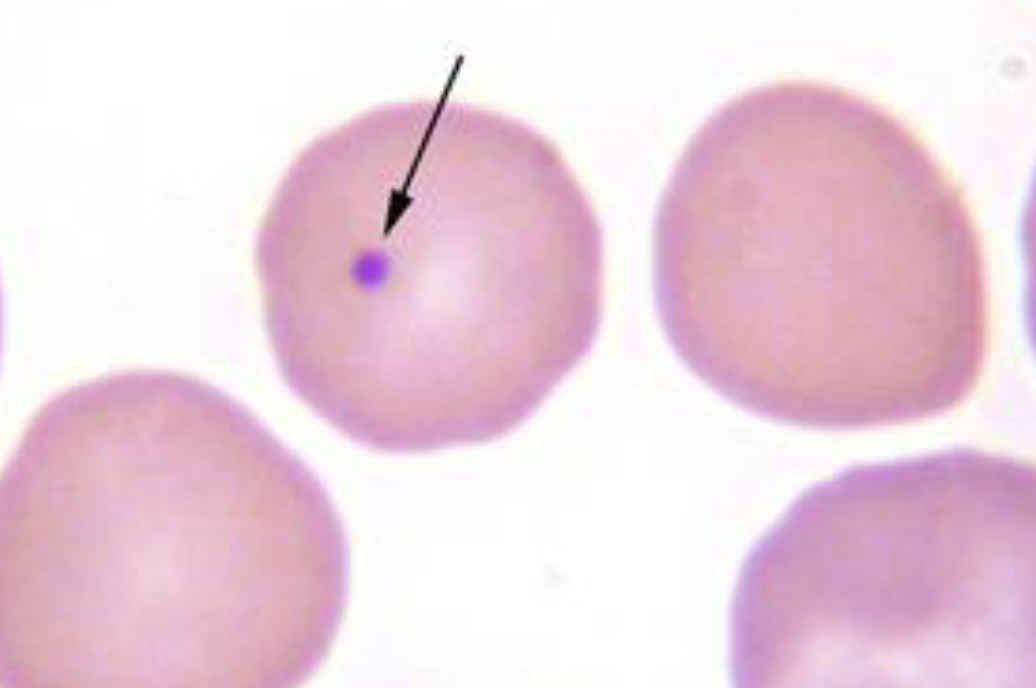
<p>Howell-Jolly Bodies </p>
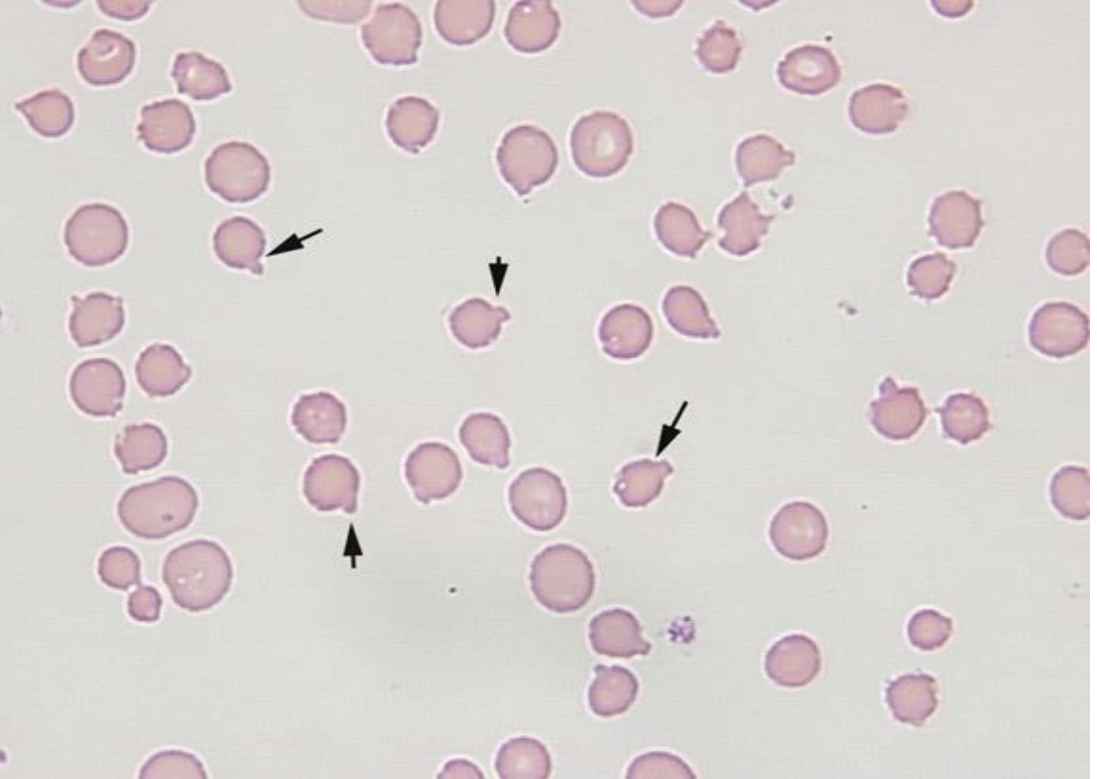
<p>What type of red blood cell is this?</p>
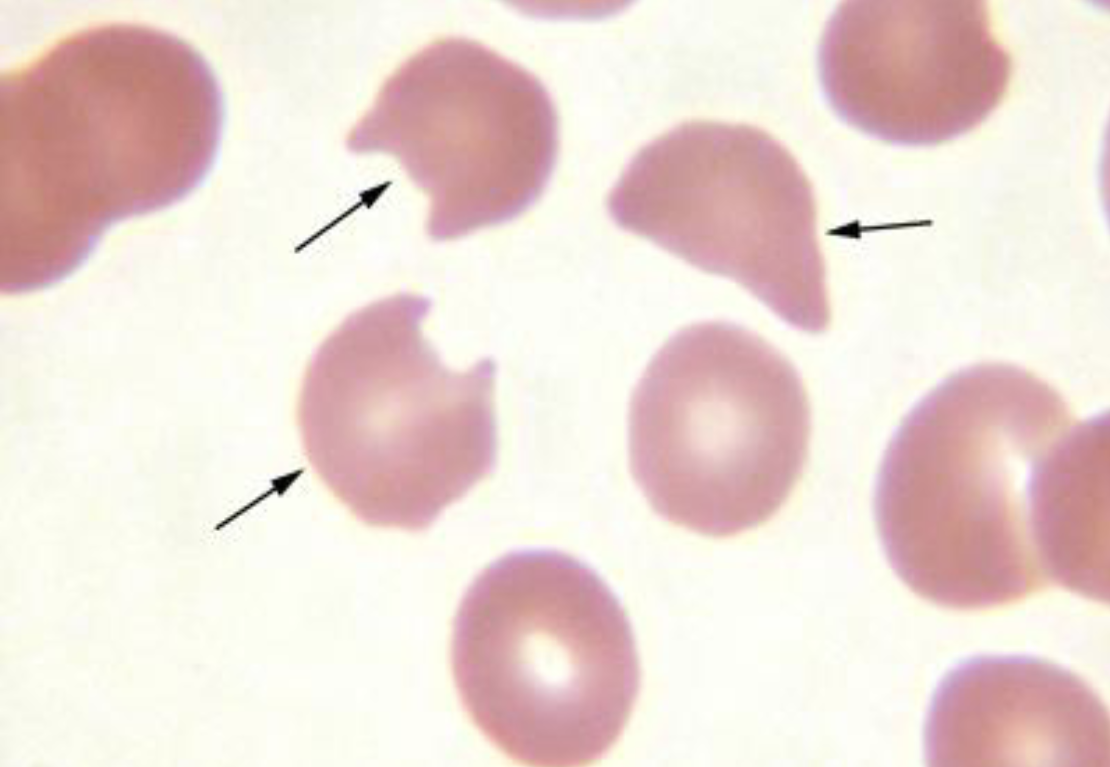
<p>Schistocyte </p>
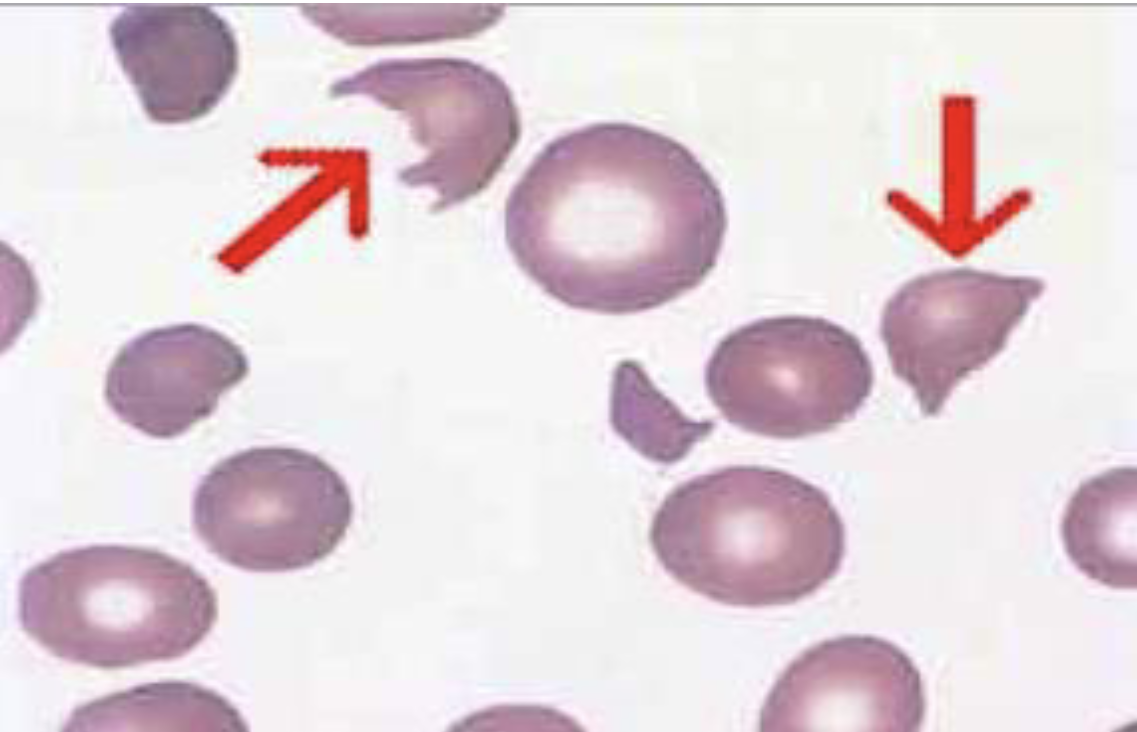
<p>Keratocyte </p>
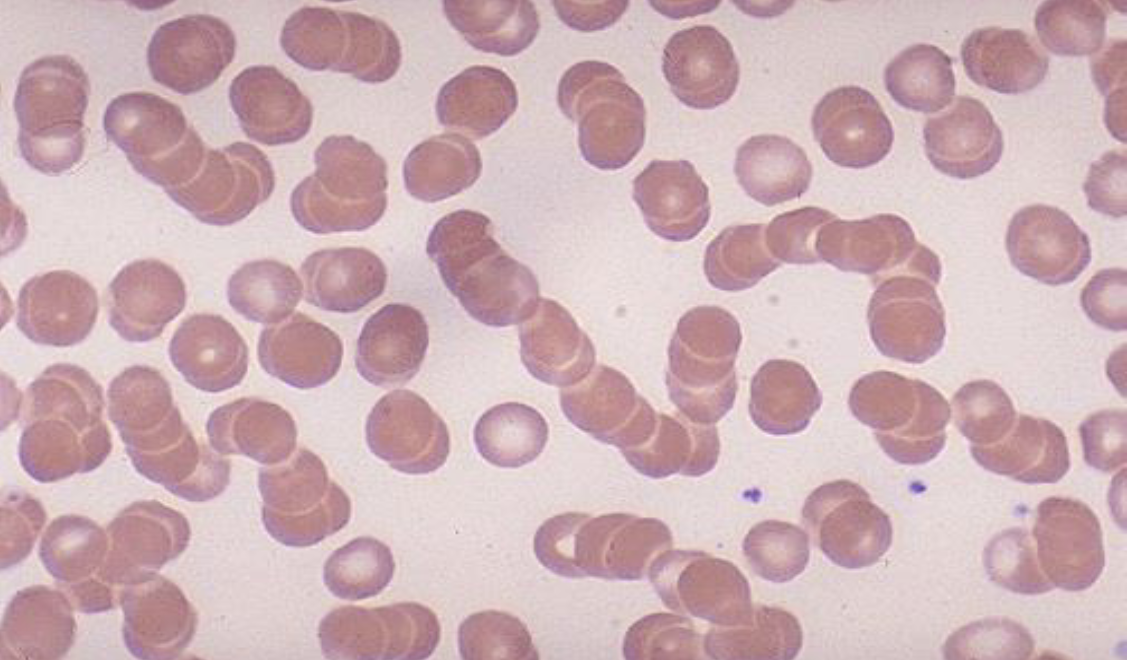
<p>Rouleaux </p>
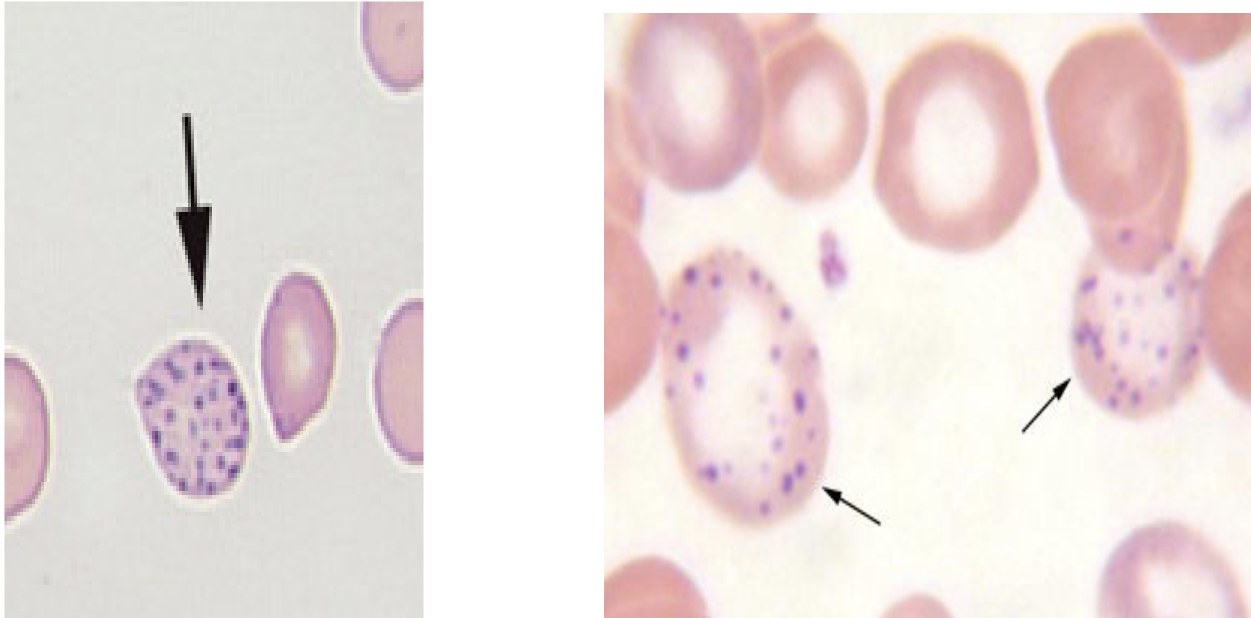
<p>Basophilic Stippling </p>
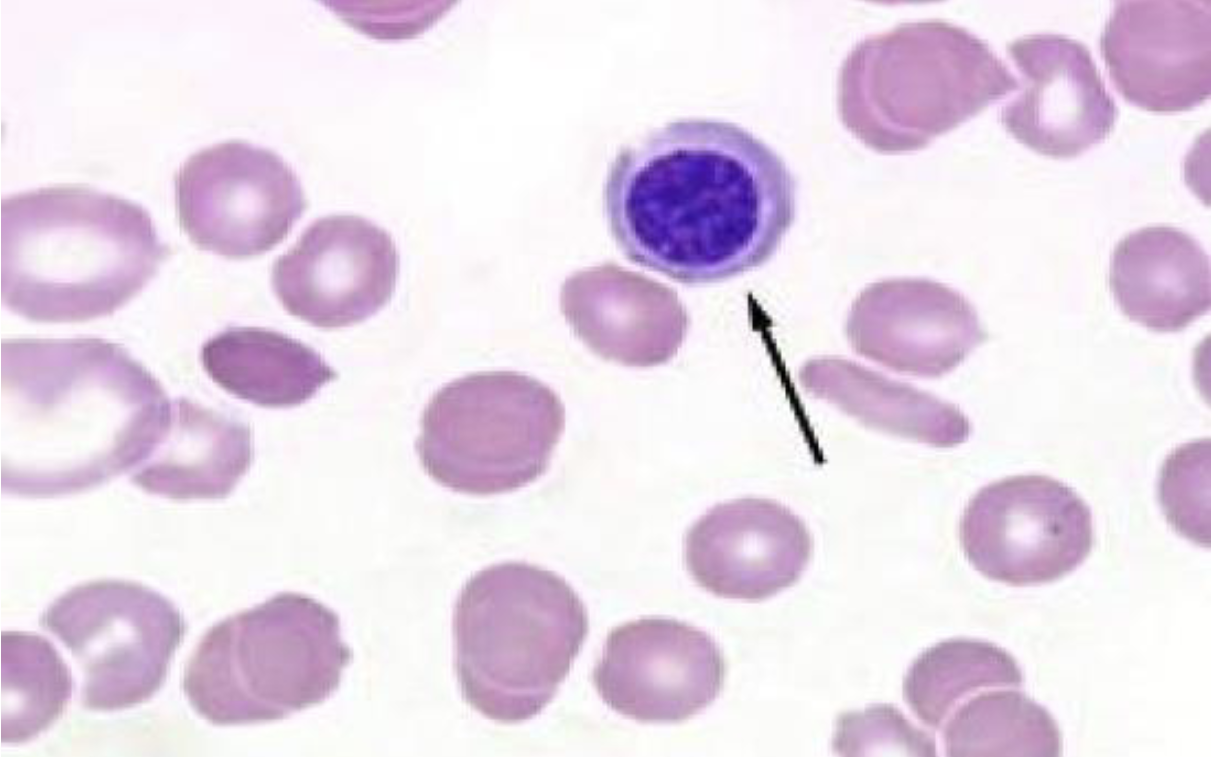
<p>Nucleated Red Blood Cell </p>
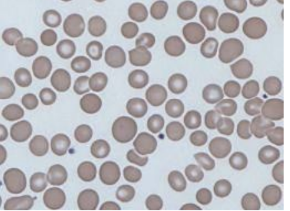
<p>What type of red blood cell?</p>
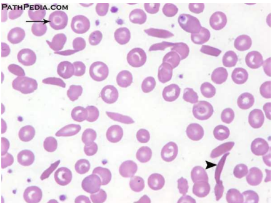
<p>Sickle Cell </p>

Red Blood Cells (Erythrocytes)
0.0(0)
Studied by 0 peopleCard Sorting
1/11
There's no tags or description
Looks like no tags are added yet.
Last updated 10:04 PM on 3/29/26
Name | Mastery | Learn | Test | Matching | Spaced | Call with Kai |
|---|
No analytics yet
Send a link to your students to track their progress
12 Terms
1
New cards
What type of red blood cell is this?
Acanthocytes
2
New cards
What type of red blood cell is this?
Target Cells
3
New cards
What type of red blood cell is this?
Howell-Jolly Bodies
4
New cards
What type of red blood cell is this?
Heinz Body
5
New cards
What type of red blood cell is this?
Echinocytes

6
New cards
What type of red blood cell is this?
Schistocyte
7
New cards
What type of red blood cell is this?
Keratocyte
8
New cards
What type of red blood cell is this?
Rouleaux
9
New cards
What type of red blood cell is this?
Basophilic Stippling
10
New cards
What type of red blood cell is this?
Nucleated Red Blood Cell
11
New cards
What type of red blood cell?
Anisocytes
12
New cards
What type of red blood cell?
Sickle Cell